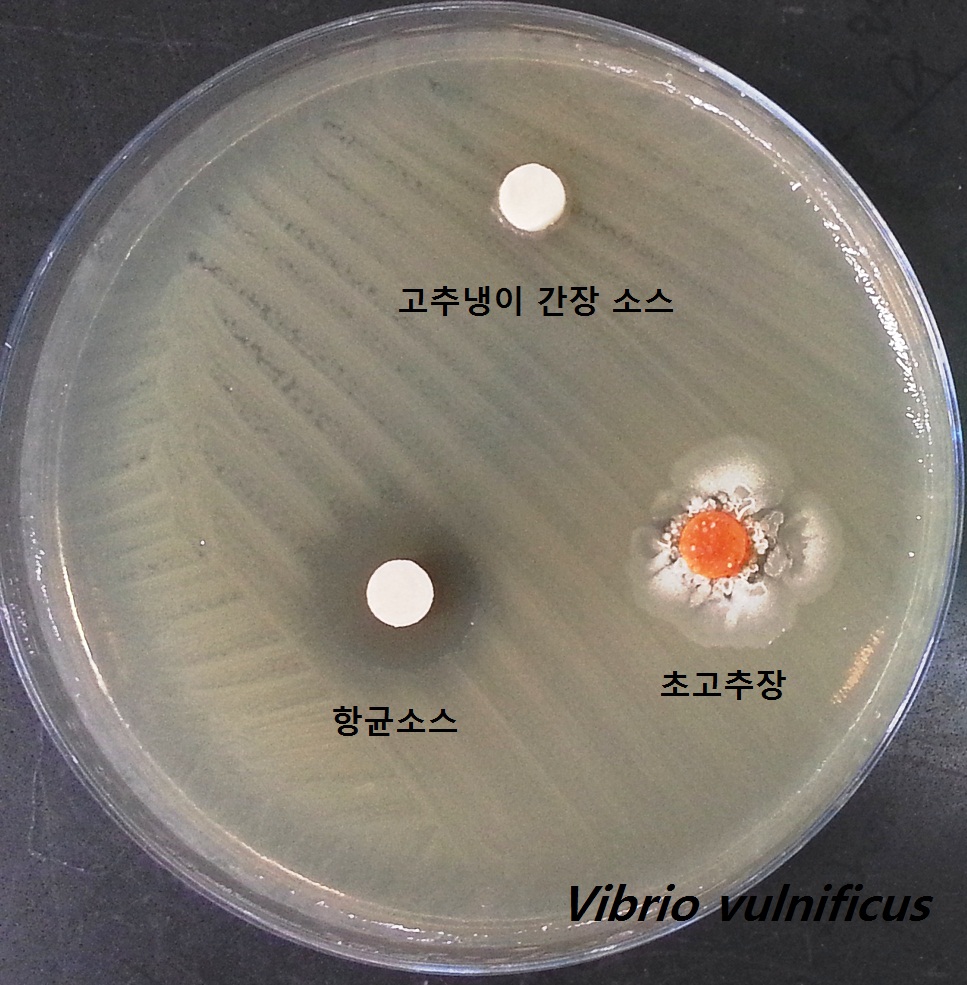
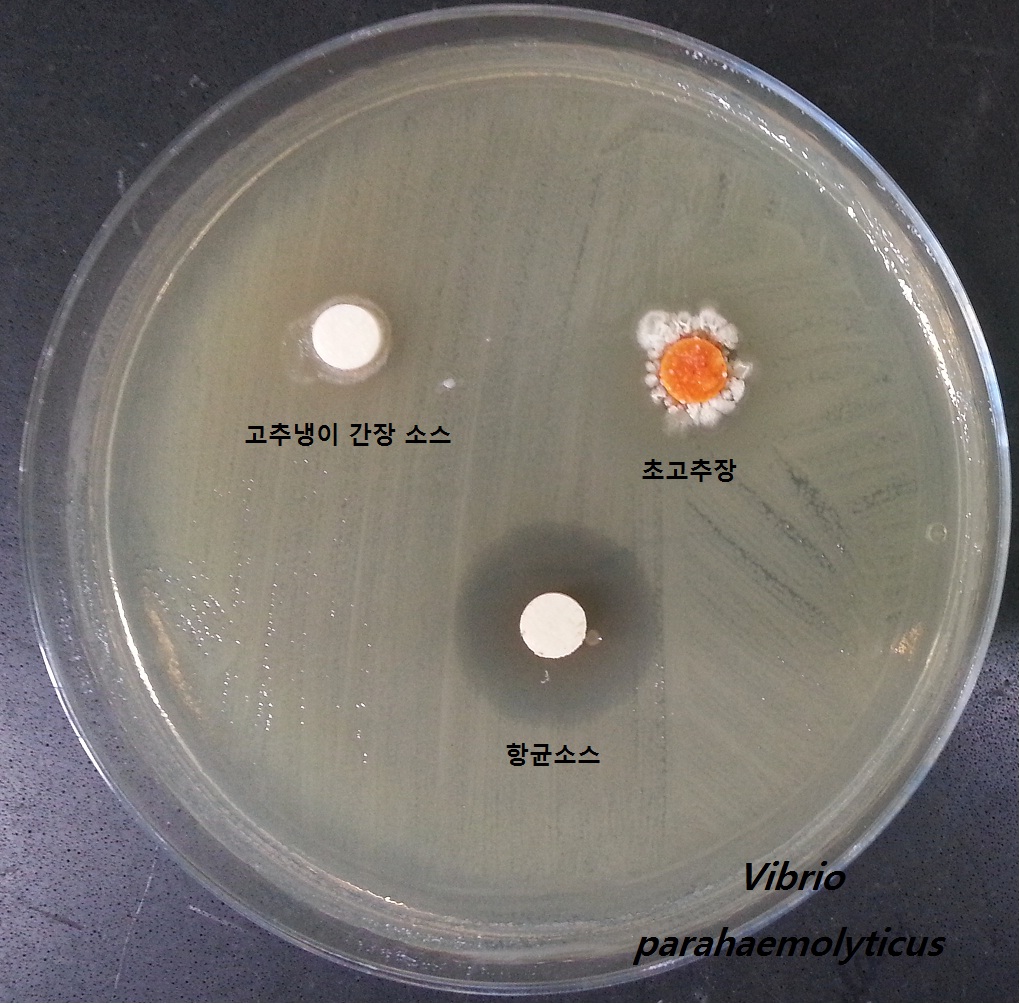

군정뉴스
- HOME
- 군정24
- 군정뉴스
강화군, 마늘식초를 이용한 생선회 식중독 항균소스 개발, 특허등록 쾌거!
- 작성자
- 본청/기획감사실(-)
- 작성일
- 2015년 5월 21일(Thu) 21:12:22
- 조회수
- 584
강화군, 마늘식초를 이용한 생선회 식중독 항균소스 개발, 특허등록 쾌거!
강화군, 인천보건환경연구원과 생선회 항균 소스 공동 개발. 식중독 걱정 끝!
강화군(군수 이상복)은 인천시보건환경연구원(원장 이성모)과의 공동연구로 생선회 항균 소스를 개발하고 항균 소스와 제조방법을 특허로 등록했다고 밝혔다.
날씨가 더워지면 어김없이 들려오는 뉴스 중 하나가 집단 식중독이다. 그 중 생선회 식중독의 주원인균은 장염비브리오균(Vibrioparahaemoliticus)이며, 비브리오패혈증 원인균은 비브리오불니피쿠스균(Vibrio vulnificus)이다. 특히, 비브리오패혈증은 여름철 해수온도가 20℃이상 되면 해안지역을 중심으로 발생하며, 면역기능이 떨어진 사람들에게 잘 발생하는데 치사율이 50%이상에 달한다.
이로 인해 여름철에는 생선회 섭취에 대한 불안감이 커져 횟집, 일식집 등 음식점에서의 생선회 소비량이 급감해 비수기에 접어들고, 지역경제의 일시적 적신호 요인이 되고 있다.
앞으로는 여름철에 생선회를 먹고 식중독이나 비브리오패혈증에 걸릴 염려를 덜 것으로 보인다.
강화군과 인천보건환경연구원은 작년 초부터 생선회 섭취에 따른 식중독 예방을 위한 공동 연구에 착수했다.
약 1년간의 연구 끝에 두 기관은 강화군 농업기술센터내 농산물가공기술관에서 제조한 마늘식초를 이용해 생선회 항균 소스를 개발하는데 성공했으며, 지난 5월 초 정식 특허를 등록(제10-1519802호)함으로써 인천시 지적재산권으로 확보했다.
기존의 생선회 양념장으로 사용되고 있는 초고추장은 비브리오균에 대해 약간의 항균력을 갖고는 있지만, 고추냉이(와사비) 간장은 항균력이 없었다. 하지만, 이번에 개발된 항균 소스는 생선회 식중독과 비브리오패혈증의 원인이 되는 두 비브리오균 모두에 항균력을 가지고 있는 것으로 나타났다.
따라서, 항균 소스와 고추장 또는 간장을 1대1로 섞은 후 생선회를 충분히 적셔서 섭취하거나 생선회나 생선초밥에 항균 소스를 스프레이해 활용하면 식중독 걱정없이 안전한 생선회 섭취가 가능할 것으로 보인다.
강화군 농업기술센터와 인천시보건환경연구원 관계자는 “지역경제 활성화를 위해 관내 업체를 공모해 항균 소스 관련 기술을 이전하고 최대한 빠른 시일 내에 상용화할 수 있도록 하겠다.”고 말했다.
 비브리오패혈증균에_대한_항균력.jpg
비브리오패혈증균에_대한_항균력.jpg